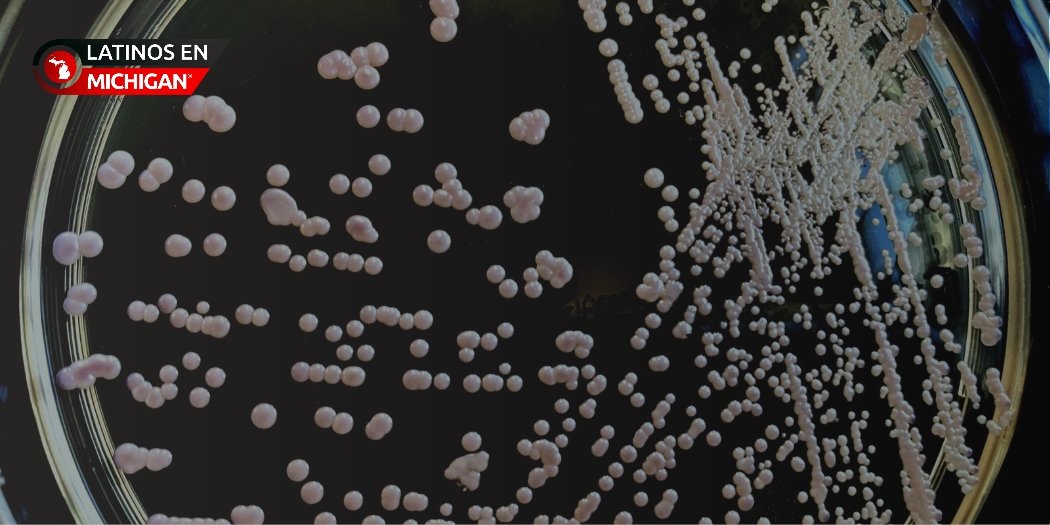

Alerta sanitaria por brote de listeria vinculado a comidas preparadas con pasta
Las autoridades sanitarias estadounidenses han emitido una alerta nacional tras confirmar un brote de listeriosis relacionado con productos de pasta listos para consumir. Según el informe más reciente de los Centros para el Control y la Prevención de Enfermedades (CDC), al menos seis personas han fallecido y 25 han sido hospitalizadas en 18 estados del